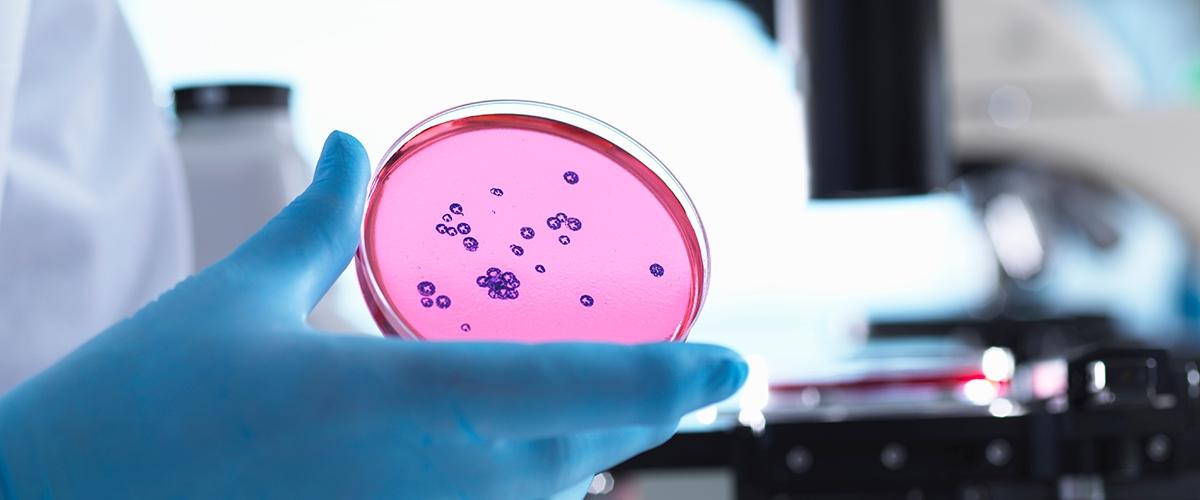
TODO:

Всего за несколько лет технология CRISPR превратилась в самую популярную методику генного редактирования. Ее применяют в биологических исследованиях, а также для улучшения свойств сельскохозяйственных растений и животных. Но далеко не все эксперты уверены в безопасности технологии. Новые исследования, о которых рассказывает Science Magazine, подкрепляют позиции скептиков.
Согласно выводам двух независимых групп из Китая, некоторые разновидности CRISPR приводят к многочисленным нецелевым мутациям.
Исследователи изучали модификацию CRISPR, которая разрезает только одну нить ДНК и заменяет не целые гены, а отдельные «буквы»-нуклеотиды с помощью фермента деаминазы.
Считается, что такие редакторы работают на более тонком уровне. Но это не предохраняет от ошибок. А как раз наоборот: как показали опыты с генами риса, инструмент для замены цитозина на тимин удваивает уровень мутаций на нецелевых участках генома.
В этот момент участники эксперимента были так удивлены его результатами, что решили отложить публикацию.
Однако их коллеги, работавшие с мышами, обнаружили еще более серьезный эффект. В их исследовании редактирование увеличило уровень мутаций в 20 раз. Причем многие из них проявились в регионах, связанных с развитием рака. При этом редактор, заменявший другие азотистые основания — аденин на гуанин — таких ошибок не совершал.
Эксперты отмечают, что даже с учетом серьезного роста частота мутаций остается достаточно низкой, чтобы применять технологию в лаборатории. Однако в медицине этот редактор оснований использовать уже слишком рискованно, предупреждают они.
Дальнейшие исследования должны показать, какой компонент редактора ответствен за побочные мутации. Возможно, тогда методику исправят, сделав ее безопасной.
Швейцарская компания CRISPR Therapeutics первой на Западе применила генное редактирование для лечения наследственного заболевания — бета-талассемии. В клинических испытаниях методики примут участие 45 человек. Ранее CRISPR использовали только в больницах Китая — с переменным успехом.